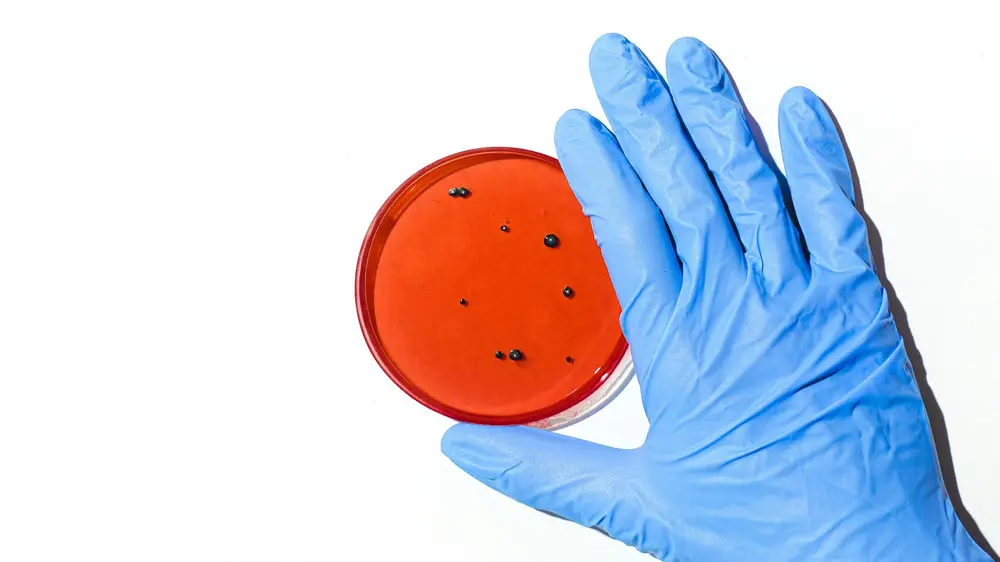

31/03/2026
Christeyns renforce sa stratégie de croissance internationale avec deux nouvelles acquisitions en Europe et en Afrique. La société acquiert des participations majoritaires dans la société finlandaise Kemvit Oy et dans la société sud-africaine Orlichem (Pty) Ltd.

08/11/2023
Grâce à l'utilisation de capteurs, le processus de NEP peut se dérouler de manière efficace et efficiente. Ainsi, non seulement la consommation d'eau et d'énergie diminue, mais les pertes de produits sont également réduites. De plus, le temps de nettoyage gagné signifie du temps de production supplémentaire.

16/10/2023
Les exigences légales en matière de production d'aliments et de boissons sont de plus en plus strictes. Pour se concentrer pleinement sur la production, de nombreuses entreprises confient le nettoyage à des partenaires externes. Quels en sont les avantages et que pouvez-vous attendre de ces partenaires?

14/02/2023
Les biofilms dans l'industrie alimentaire peuvent avoir des conséquences majeures, sous la forme d'altération des aliments, de contamination des aliments et de rappels de produits alimentaires. Un nouveau projet mené par l'ILVO devrait permettre de mieux comprendre le contrôle et l'élimination.
09/11/2020
Les récentes épidémies et les nouvelles techniques d'analyse montrent que même de petites concentrations de listeria peuvent avoir de lourdes conséquences. L'absence totale semble donc être le nouvel objectif, bien que cela ne soit pas réalisable dans certains secteurs.

26/08/2020
Dans une entreprise alimentaire, celui qui ne s'attaque pas à la pollution à la source, ne verra pas son problème résolu avec la brumisation. Toutefois, celle-ci peut être une manière supplémentaire de réduire un peu le problème des bactéries dans les entreprises présentant un risque de contamination plus élevé.

10/06/2020
Le choix d‘un détergent pour libérer un appareil des résidus de produits est une tâche exigeante. En suivant plusieurs étapes de manière systématiques, vous parviendrez à sélectionner vous-même le détergent le plus approprié pour votre application, avec ou sans l‘aide du fournisseur.

06/05/2020
Les techniques de nettoyage à sec traditionnelles sont inconnues de nombreuses entreprises alimentaires. C'est encore plus le cas des méthodes alternatives. Pourtant, beaucoup d'entre elles sont considérées comme une opportunité pour récupérer des résidus de produit, ce qui constitue un avantage supplémentaire important.

27/04/2020
Qui pense nettoyage, pense automatiquement solution de détergents. Dans certains cas, un nettoyage à sec est recommandé. En outre, il peut afficher de gros avantages par rapport à la variante mouillée.

31/01/2019
Dans l'industrie alimentaire, les exigences en termes d'hygiène et de sécurité alimentaire sont très strictes. Cela concerne aussi les composants et les lubrifiants utilisés. Les tendances récentes et les avancées concernent surtout les lubrifiants 'direct contact' (3H), les éléments polluants des emballages qui se retrouvent dans les aliments (mais qui sont aussi présents dans les lubrifiants), et le fameux phénomène des 'allergènes'.

13/12/2017
Il existe de nombreux produits chimiques sur le marché, chacun avec une action spécifique et d'importants avantages et désavantages pour la santé de l'utilisateur ou l'environnement. Comment sélectionner la bonne chimie pour votre nettoyage et désinfection, et quels facteurs sont importants?

29/11/2017
Avant de libérer une installation alimentaire pour la production, il peut être nécessaire de la soumettre à un test allergénique après nettoyage et désinfection. Vous pouvez effectuer un test ATP rapide pour cela, mais dans certains cas un test allergénique plus spécifique et plus efficace est recommandé.

29/11/2017
Les huiles et graisses organiques rongent les conduites, entraînent des obstructions et des nuisances olfactives, et surchargent les installations d’épuration des eaux. Les jauges d’épaisseur de la couche de graisse aident à optimiser les intervalles de vidange et minimiser les coûts de vidange.

29/11/2017
Parce que l'industrie alimentaire emploie généralement des personnes de nationalités différentes et que le personnel travaille parfois, il est important d'établir des procédures standard pour le nettoyage et la désinfection. Sur un tel SSOP (Standard Sanitation Operating Procedure), toutes les actions et aides doivent être décrites de manière précise, claire et détaillée.

29/11/2017
Le choix entre le nettoyage à sec ou par voie humide dépend de l'environnement de production et des aliments transformés. Dans les deux cas, il y a sept étapes à suivre.
29/11/2017
Celui qui s'interroge sur les désinfectants écologiques, doit commencer par examiner attentivement ses résultats de nettoyage. Le processus de désinfection le plus durable commence par un prénettoyage optimal. Quand aux désinfectants même, on observe une tendance aux désinfectants garantis sans résidus, qui ne doivent plus être post-rincés.

29/11/2017
La salmonelle et la listeria trouvent facilement leur chemin vers les abattoirs de poulets et de porcs. Un abattoir complètement exempt de bactéries est-il réalisable? Et quelle est la 'best practice', d'éradiquer ou d'éviter une contamination? Ceci était le sujet d'une table ronde avec des professionnels du secteur de la recherche et de l'entreprise.

29/11/2017
Avant Quality Days, plusieurs acteurs du monde de l'entreprise et de la recherche ont été conviés à une table ronde intéressante. Cette fois, la discussion était placée sous le signe des biocides, qui suscitent de plus en plus l'attention du secteur alimentaire et des instances en charge des audits. Des scientifiques, fabricants de désinfectants et autres spécialistes se sont exprimés sur le danger des biocides, la législation en la matière et les alternatives possibles pour l'avenir.

29/11/2017

29/11/2017
La législation relative aux pesticides a fortement durci les règles concernant la présence de chlorate - un sous-produit du chlore - dans les produits alimentaires. Si l'on envisage de travailler à l'international, on a intérêt à viser une tolérance zéro et à envisager d'autres techniques disponibles. Voici un aperçu des différentes possibilités, avec leurs principes de fonctionnement, leurs atouts et leurs applications possibles.